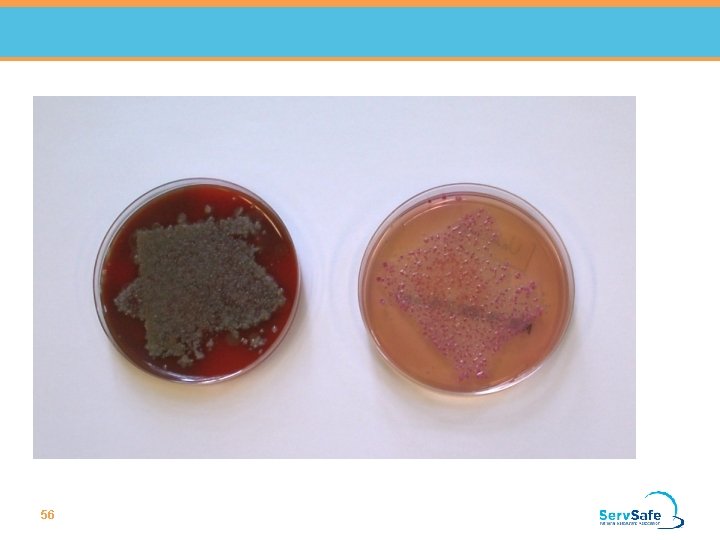
56 56

Food Safety Is Important Food Safety Is Important

- Slides: 74
Food Safety Is Important
Food Safety Is Important Concepts You Will Learn l How food becomes unsafe l Your role in keeping food safe l Identify the causes of foodborne illness l Explain the consequences of foodborne illness
The Importance of Food Safety Food safety is the responsibility of every employee. If you fail to follow proper food safety principles, your coworkers and your customers can get sick. Safe Food is food that is free of contaminants. 4
5
Symptoms, Onset Times and Duration Symptoms of foodborne illness include: • Stomach cramps • Diarrhea • Vomiting • Nausea • Fever 6
Populations at High Risk for Foodborne Illnesses Higher Risk People l Elderly people l Infants and preschoolage children l Pregnant women l People with cancer or on chemotherapy l People with HIV/AIDS l Transplant recipients 7
How Food Becomes Unsafe Hazards from the Environment X X Biological Page 1 -1 X Chemical Physical
What type of hazard are pest? 9
How Food Becomes Unsafe Page 1 -2
Good Personal Hygiene
12
How And When To Wash Your Hands Why is Handwashing Important? l Hands can transfer pathogens to food. l Handwashing is a critical step for avoiding food contamination. Page 2 -1
Why is Handwashing Important? Dirty and Clean hands 14
How And When To Wash Your Hands How to Wash Your Hands Step 1: Wet hands and arms l Use running water as hot as you can comfortably stand. Page 2 -1
How And When To Wash Your Hands How to Wash Your Hands Step 2: Apply soap l Apply enough to build up a good lather. Page 2 -1
How And When To Wash Your Hands How to Wash Your Hands Step 3: Scrub hands and arms vigorously l Scrub them for 10 to 15 seconds. l Clean under fingernails and between fingers. Page 2 -1
How And When To Wash Your Hands How to Wash Your Hands Step 4: Rinse hands and arms thoroughly l Use running warm water. Page 2 -1
How And When To Wash Your Hands How to Wash Your Hands Step 5: Dry hands and arms l DO NOT use your apron or uniform. l Do use a single-use paper towel or a hand dryer. Page 2 -1
How And When To Wash Your Hands What Should You do After Washing Your Hands? Use a paper towel to: l Turn off the faucet. l Open the restroom door. Page 2 -2
How and When To Wash Your Hands Using Hand Antiseptics If you use hand antiseptics: l NEVER use them instead of handwashing. l Use an antiseptic after washing hands. l Wait for the antiseptic to dry before touching food or equipment, or putting on gloves. l Follow the manufacturer’s directions. Page 2 -4
Other Hand-Care Guidelines Use Gloves Correctly l DO NOT touch ready-to -eat food with bare hands. l Only use single-use gloves when handling food. Page 2 -6
Other Hand-Care Guidelines What’s Wrong With This Picture? The gloves are being put on incorrectly Page 2 -6
Other Hand-Care Guidelines What’s Wrong With This Picture? The gloves are being washed and reused Page 2 -6
Other Hand-Care Guidelines When Should Gloves be Changed? l As soon as they become dirty or torn. Page 2 -6
Hand Care Requirements for Foodhandlers Keep fingernails short and clean Do not wear false nails Bandage wounds and cover bandages Do not wear nail polish 26
Proper work attire Foodhandlers should: l Wear a clean hat or other hair restraint l Wear clean clothing daily l Remove aprons when leaving food-preparation areas l Remove jewelry from hands and arms before prepping food or when working around prep areas 27
Other Important Practices Eating, Drinking, Smoking, or Chewing Gum NEVER do these things in the following areas: o In prep areas o In areas used to clean utensils and equipment o In service areas Page 2 -9 X
Other Important Practices What to do if You are Sick l Tell your manager if you are sick. l Tell your manager if you have any of these symptoms: o Vomiting o Diarrhea o Jaundice (yellowing of skin and eyes) o Sore throat with a fever Page 2 -10
Controlling Time and Temperature
31
Bacteria • Classifications o Intoxication: An illness caused when bacteria produce exotoxins that are released into food; short onset time. o Infection: A disease caused by the release of endotoxins in the intestine of the affected person; has a 1 -2 day onset time 32
FAT TOM • FAT TOM: The acronym that lists the conditions that support the rapid growth of bacteria. These conditions are: o. F o. A o. T o. O o. M 33
FAT TOM • FAT TOM: The acronym that lists the conditions that support the rapid growth of bacteria. These conditions are: o Food – Protein o Acidity – p. H<7. 0 o Time – Around 20 minutes o Temperature – 41ºF (5ºC) and 135ºF (57ºC) o Oxygen – Specific to bacteria o Moisture – a 0. 95 – 0. 99 34
Why Controlling Time and Temperature Is Important Which Good Needs Time and Temperature Control for Safety? A B Poultry Page 3 -1 Fish
Why Controlling Time and Temperature Is Important A Which Food Needs Time and Temperature Control for Safety? B C Milk and dairy Page 3 -1 Baked potatoes
Why Controlling Time and Temperature Is Important A Which Food Needs Time and Temperature Control for Safety? B Meat: Pork Page 3 -1 C Heat-treated plant food
Why Controlling Time and Temperature Is Important A Which Food Needs Time and Temperature Control for Safety? B Sprouts and sprout seeds Page 3 -1 C Shell eggs Sliced melons, cut tomatoes, cut leafy greens
Why Controlling Time and Temperature Is Important Which Food Needs Time and Temperature Control for Safety? A Untreated garlic and oil mixtures Page 3 -1 B Meat: Beef and lamb
Why Controlling Time and Temperature Is Important What is Important About This Temperature Range? This is the temperature danger zone. Pathogens on food can grow in this range and cause a foodborne illness. Page 3 -2
How to Calibrate Thermometers Ice-Point Method Boiling-Point Method Adjust the thermometer so it reads 32˚F (0˚C). so it reads 212˚F (100˚C). 41
Controlling Time and Temperature From Receiving Through Preparation What are Some Ways You Can Store TCS Food Safely? l Store cold TCS food at 41˚F (5˚C) or lower. l Keep frozen food frozen. l DO NOT overload coolers or freezers. Plan ahead to avoid opening cooler doors Page 3 -5 l
Proper storage Preventing Cross-Contamination l Store food items in the following l 43 top-to-bottom order: o Ready-to-eat food o Seafood o Whole cuts of beef and pork o Ground meat and ground fish o Whole and ground poultry
Controlling Time and Temperature From Receiving Through Preparation Storing TCS Food Safely l All food stored out of its original container must be labeled. l The label must contain the common name of the food. l The mark must indicate when the food must be sold, eaten, or thrown out. Store RTE TCS food for seven Page 3 -5 maximum. days l
Controlling Time and Temperature From Receiving Through Preparation Storing TCS Food Safely 1. Check the use-by or expiration date. 2. Store items that will expire first in front of those that will expire later (FIFO). 3. Use the food in front first. Page 3 -5
Controlling Time and Temperature From Receiving Through Preparation Four Acceptable Ways to Thaw TCS Food Page 3 -6
Controlling Time and Temperature when Cooking, Holding, Cooling, and Reheating Cooking TCS Food l Cooking reduces pathogens in food to safe levels. Page 3 -8
Controlling Time and Temperature when Cooking, Holding, Cooling, and Reheating What Internal Temperature Should Poultry be Cooked to? Poultry l 165˚F (74˚C) for 15 seconds Page 3 -8
Controlling Time and Temperature when Cooking, Holding, Cooling, and Reheating Cooling Methods There are many ways to cool food quickly and safely. l Ask your manager what method to use. Page 3 -10
Controlling Time and Temperature when Cooking, Holding, Cooling, and Reheating TCS Food for Hot-Holding l Heat TCS food to an internal temperature of 165˚F (74˚C) for 15 seconds. l The food must reach this temperature within two hours. Page 3 -10
Preventing Cross-Contamination
52
Preventing Cross-Contamination of Food Preventing Cross. Contamination During Receiving l Keep contaminated food out of the operation. l Reject food if it has these problems: o Damaged packaging o Water stains o Leakage o Signs of pests Page 4 -1 X
Preventing Cross-Contamination of Food What’s Wrong With the Way This Food has Been Stored? l Wrap or cover it. o This can stop contaminants from falling into food. The food is uncovered Page 4 -1
55
56
Preventing Cross-Contamination of Food Preventing Cross. Contamination When Prepping Food l Make sure items used during preparation are cleaned and sanitized. o Workstations o Cutting boards o Equipment o Utensils Page 4 -2
Preventing Cross-Contamination of Food What Safety Practices Should be Followed When Washing Produce? When washing produce: l Clean and sanitize the prep sink. l Wash produce in running water slightly warmer than the food. l Pull leafy greens apart. Page 4 -2
What To Do For People Who Have Food Allergies What are the Most Common Food Allergens? Page 4 -9
What To Do For People Who Have Food Allergies The Most Common Food Allergens Page 4 -9
Symptoms of an allergic reaction include: l l l l 61 Itching in and around the mouth, face, or scalp Tightening in the throat Wheezing or shortness of breath Hives Swelling of the face, eyes, hands, or feet Abdominal cramps, vomiting, or diarrhea Loss of consciousness Death
Cleaning and Sanitizing
63
How And When To Clean And Sanitize What is the Difference Between Cleaning and Sanitizing? l Cleaning removes food and other dirt from surfaces. l Sanitizing reduces pathogens on surfaces to safe levels. Page 5 -1
How And When To Clean And Sanitize How to Clean and Sanitize Surfaces 1. Scrape or remove food from the surface. Page 5 -2
How And When To Clean And Sanitize How to Clean and Sanitize Surfaces 2. Wash the surface. Page 5 -2
How And When To Clean And Sanitize How to Clean and Sanitize Surfaces 3. Rinse the surface. Page 5 -2
How And When To Clean And Sanitize How to Clean and Sanitize Surfaces 4. Sanitize the surface. Page 5 -2
How And When To Clean And Sanitize How to Clean and Sanitize Surfaces 5. Allow the surface to air-dry. Page 5 -2
Ventilation Systems l l 70 If adequate, there will be little buildup of grease and condensation on walls and ceilings Hoods, fans, and ductwork must not drip onto food or equipment Hood filters or grease extractors must be tight fitting and cleaned regularly Hoods and ductwork must be cleaned periodically by professionals
How And When To Clean And Sanitize When to Clean and Sanitize l Before you start working with a different type of food. Page 5 -3
How And When To Clean And Sanitize When Should Items be Cleaned and Sanitized? l After you are done using an item. Page 5 -3
Handling Garbage Is the Garbage Being Handled Correctly? Why or Why Not? l Remove garbage from prep areas as quickly as possible. l Be careful not to contaminate food or surfaces when removing garbage. Page 5 -10 No. The garbage is touching the prep table
Handling Garbage Is the Garbage Container Being Handled Correctly? Why or Why Not? l DO NOT clean garbage containers near prep or food-storage areas. l Clean the inside and outside of garbage containers often. Page 5 -10